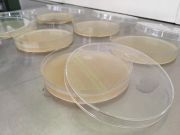

This special page shows all uploaded files.
| Date | Name | Thumbnail | Size | Description | Versions |
|---|---|---|---|---|---|
| 23:17, 22 January 2017 | Aufbau-einer-mikrobiellen-Batterie.jpg (file) |  |
2.59 MB | 2 | |
| 23:05, 22 January 2017 | Aufbau einer mikrobiellen Batterie.jpg (file) |  |
2.53 MB | 2 | |
| 22:52, 22 January 2017 | Sterilisieren-Versuch1.gif (file) | Error creating thumbnail: convert convert: Unrecognized option (-layers).
Error code: 1 |
2.8 MB | File uploaded with MsUpload | 1 |
| 21:22, 22 January 2017 | Konzept-Skizze2.jpg (file) |  |
342 KB | 2 | |
| 21:09, 22 January 2017 | Damocles-Sword.gif (file) | Error creating thumbnail: convert convert: Unrecognized option (-layers).
Error code: 1 |
122 KB | File uploaded with MsUpload | 1 |
| 21:05, 22 January 2017 | Damocles.tiff (file) | 283 KB | 2 | ||
| 20:41, 22 January 2017 | Selbstgemachtes Nährmedium.jpg (file) | |
1.55 MB | File uploaded with MsUpload | 1 |
| 20:40, 22 January 2017 | Schleimpilz sollte zur Nahrung wachsen.jpg (file) |  |
1.46 MB | File uploaded with MsUpload | 1 |
| 20:11, 22 January 2017 | Fertiger Versuchsaufbau.jpg (file) |  |
1.9 MB | File uploaded with MsUpload | 1 |
| 20:09, 22 January 2017 | Schlamm aus einem Bach.jpg (file) |  |
1.64 MB | File uploaded with MsUpload | 1 |
| 20:09, 22 January 2017 | Abstrich unter dem Mikroskop untersuchen.jpg (file) |  |
1.53 MB | File uploaded with MsUpload | 1 |
| 20:08, 22 January 2017 | Organismen in Pertischale kultivieren.jpg (file) |  |
1.66 MB | File uploaded with MsUpload | 1 |
| 20:05, 22 January 2017 | Schleimpilzwiedererweckung.gif (file) | Error creating thumbnail: convert convert: Unrecognized option (-layers).
Error code: 1 |
3.87 MB | File uploaded with MsUpload | 1 |
| 19:49, 22 January 2017 | Sichtung mit DSLR Kamera.jpg (file) |  |
1.75 MB | File uploaded with MsUpload | 1 |
| 19:49, 22 January 2017 | Der Brutschrank.jpg (file) |  |
1.56 MB | File uploaded with MsUpload | 1 |
| 19:40, 22 January 2017 | Typischer Arbeitsplatz.jpg (file) |  |
1.89 MB | File uploaded with MsUpload | 1 |
| 23:42, 8 November 2016 | 0-2.jpg (file) |  |
1.56 MB | File uploaded with MsUpload | 1 |
| 23:42, 8 November 2016 | 0-1.jpg (file) |  |
1.89 MB | File uploaded with MsUpload | 1 |
| 23:35, 8 November 2016 | Microscopy-1.jpg (file) |  |
1.66 MB | File uploaded with MsUpload | 1 |
| 23:35, 8 November 2016 | Microscopy-2.jpg (file) |  |
1.53 MB | File uploaded with MsUpload | 1 |
| 23:35, 8 November 2016 | Microscopy-3.jpg (file) |  |
1.65 MB | File uploaded with MsUpload | 1 |
| 23:31, 8 November 2016 | Microscopy-4.jpg (file) |  |
1.75 MB | File uploaded with MsUpload | 1 |